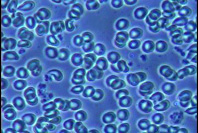
血液

特徴FEATURES
優れた分解能、美しく鮮明な画像
血液像やプラーク中の細菌などを、テレビやパソコンのモニタに鮮明に映し出すことができます。
見たいところを探しやすい!
レイマーの位相差顕微鏡は低倍~高倍率の複数の対物レンズを有しているので、ターゲットを容易に見つけ出せます。まず低倍率の対物レンズで観察し、観察したい部分を探してから高倍率に切り換え、モニタに映し出します。顕微鏡を覗くとモニタ上よりもより広い視野で観察できて便利です。
また、メカニカルステージは操作性が最も高いXY同軸ハンドルです。
高い拡張性
オプション品との併用でデジタルカメラなど他の撮影機器を接続することもできます。また位相差検鏡のみならず明視野観察も可能です。暗視野検鏡などのオプションもあります。
位相差顕微鏡による血液やプラーク中の細菌の
動画はこちらでご覧下さい。
- 長寿命の高輝度白色LEDを搭載(3W、5000〜5500K、調光機構あり)
- 逆レボルバ
- 粗微動同軸焦点システム(テンション調整機構、リミットストッパー、最小目盛り0.002mm)
- 広視野接眼レンズ、アクロマート対物レンズ採用
- ワイドメカニカルステージ(125mmX135mm、可動域35mmX75mm)
- 上下機構付きアッベコンデンサ NA=1.25、コンデンサ絞り付
- 暗視野コンデンサ、写真撮影装置等のオプション有
- 瞳孔間距離調整範囲:53mm~75mm
- 入力電圧:AC100~240V
- 重量:約7Kg
- 寸法:高さ:398mm, ベース:180×222mm

またはS-Videoケーブル※1

またはS-Videoケーブル※1

※1: コンポジットケーブルとS-Videoケーブルにより2系統同時出力が可能です(2系統同時出力は1/3インチCCDカメラ1129HMNのみ対応)。
※2:パソコンの仕様にあったビデオキャプチャが必要です。パソコンによってはビデオキャプチャが不要の場合があります。
※3:ビデオ入力端子付きのテレビモニタ
| モニタ上での倍率:1/3インチCCDカメラ | 14インチモニタ | 20インチモニタ | 29インチモニタ |
|---|---|---|---|
| 10倍対物レンズ使用時 | 約590倍(1180倍) | 約840倍(1690倍) | 約1220倍(2450倍) |
| 20倍対物レンズ使用時 | 約1180倍(2370倍) | 約1690倍(3380倍) | 約2450倍(4910倍) |
| 40倍対物レンズ使用時 | 約2370倍(4740倍) | 約3380倍(6770倍) | 約4910倍(9820倍) |
| 100倍対物レンズ使用時 | 約5920倍(11850倍) | 約8460倍(16930倍) | 約12270倍(24550倍) |
※()内は2倍デジタルズーム使用時の倍率
| モニタ上での倍率:1/4インチCCDカメラ | 14インチモニタ | 20インチモニタ | 29インチモニタ |
|---|---|---|---|
| 10倍対物レンズ使用時 | 約790倍(1580倍) | 約1130倍(2260倍) | 約1640倍(3270倍) |
| 20倍対物レンズ使用時 | 約1580倍(3160倍) | 約2260倍(4520倍) | 約3270倍(6550倍) |
| 40倍対物レンズ使用時 | 約3160倍(6320倍) | 約4520倍(9030倍) | 約6550倍(13100倍) |
| 100倍対物レンズ使用時 | 約7900倍(15800倍) | 約11290倍(22580倍) | 約16370倍(32740倍) |
※()内は2倍デジタルズーム使用時の倍率
大学・研究機関、病院・医院、食品・環境関連の企業様などにご利用頂いている信頼できる位相差顕微鏡です。
CCDカメラは1/3インチCCDと1/4インチCCDの2種類をご用意しております。
画素数が同じならCCDのサイズが大きいほど変換される情報量が多くなり、より広い範囲で豊かな階調の画像が得られます。
一方、1/3インチCCDカメラよりも1/4インチCCDカメラの方がより大きな画像を得ることができます。
ご注文の際は、BX-2700TPHとCCDカメラを選択して下さい。

プラスチック製キャリーケースが付属します。持ち運びに便利です。










































